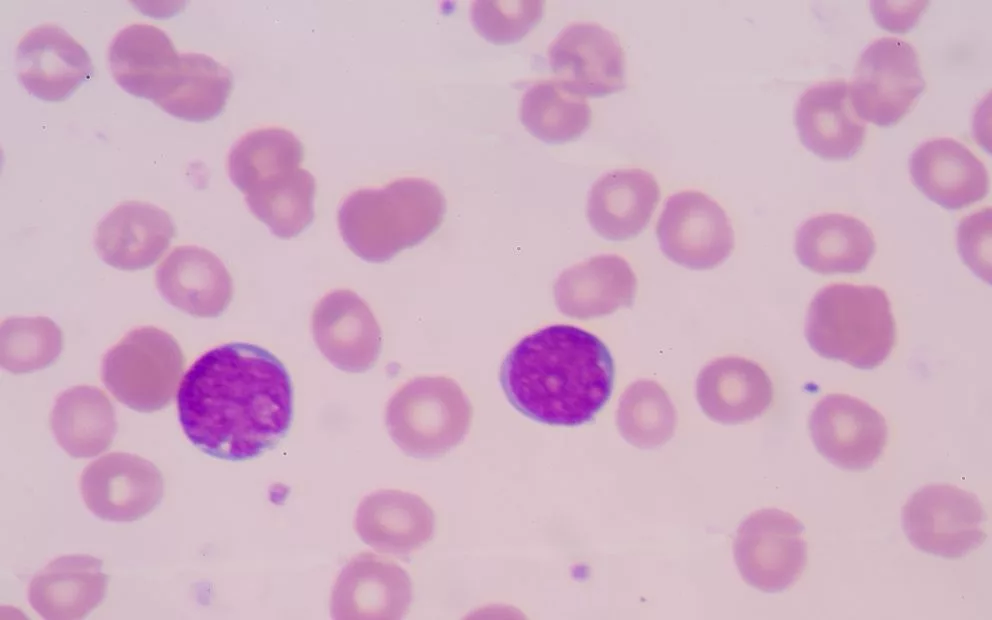

Stubborn cancer cells play a cunning trick when faced with treatments designed to kill them — they eat themselves to survive. But SAHMRI researchers have found a way to starve the cancer cells, making them more susceptible to cancer therapy.
As researchers develop more personalised cancer therapies that target cancer cells, they are also seeing an increase in resistance to treatment, where patients relapse or no longer respond to treatment.
One way that cancer resists treatment is by undergoing a process where the cancer cells eat themselves to maintain energy levels during times of stress — a process that helps them survive cancer treatments that would otherwise starve them.
Lisa Schafranek, a University of Adelaide PhD student working a SAHMRI, and her colleagues have used a clinically available drug to stop leukaemia cells from eating themselves to survive cancer therapy.
“We’ve managed to block the self-eating process at a stage where the cell would normally break down its food into energy,” says Lisa. “The cell still eats itself, but it can’t transform that food into anything useful. So in the end, the cell essentially starves by eating itself to death.
“By preventing the cancer cells from self-eating, we’re cutting off their escape route and forcing them to face the cancer therapy.”
Their treatment uses a clinically available drug, which was originally developed as an antibiotic to treat lung infections.
“Italian researchers first noticed in 2012 that leukaemia patients being treated with the antibiotic responded much better to the cancer therapy than they had before,” explains Lisa. “So we’ve taken that observation and gone further to understand more about how it actually works on a cellular level.”
As a result of these findings, a small-scale human trial of combined antibiotic–cancer therapy has recently begun in Italy.
“Right now, we’re focussing on finding effective treatment options for people suffering from leukaemia, but this research is also likely to have applications for other types of cancers such as breast or colon cancer,” says Professor Timothy Hughes, Head of Translational Leukaemia Research at SAHMRI.
This work provides a way of making current cancer treatments more effective and less likely to leave behind surviving cancer cells that might re-grow and cause a patient to relapse, or force the patient to stay on cancer treatments for the rest of their life.
Lisa Schafranek was an Australian national finalist of FameLab — a global science communication competition for early-career scientists.
Background
Lisa has recently submitted her PhD at the University of Adelaide, where she has been researching the critical survival mechanisms leukaemia cells use to evade cancer therapy. Her aim is to find new therapeutic targets to make cancer treatments more effective. She has recently finished this work at SAHMRI and is now planning on furthering her career in Melbourne.
Lisa’s work on inhibiting cancer cell autophagy (self-eating) has been published in:
Schafranek L, Leclercq TM, White DL and Hughes TP. Clarithromycin enhances dasatinib-induced cell death in chronic myeloid leukaemia cells, by inhibition of late stage autophagy. Leuk Lymphoma 2013; 54: 198–201.
And presented both locally and nationally at:
Schafranek L, Leclercq TM, White DL and Hughes TP. Overcoming resistance to tyrosine kinase inhibitors in chronic myeloid leukaemia by blocking autophagy with clarithromycin. Medical Staff Society Research Prize, May, 2013
Schafranek L, Leclercq TM, White DL, Hughes TP. Macrolide Antibiotic Clarythromycin targets TKI-induced autophagy in CML cells. HAA Annual Scientific Meeting Oct, 2012
Acknowledgements
Lisa’s research was supported by a PhD scholarship from the Leukaemia Foundation of Australia.
In 2014, the British Council and Fresh Science have joined forces to bring FameLab to Australia.
FameLab Australia will offer specialist science media training and, ultimately, the chance for early-career researchers to pitch their research at the FameLab International Grand Final in the UK at The Times Cheltenham Science Festival from 3 to 5 June 2014.
FameLab is an international communication competition for scientists, including engineers and mathematicians. Designed to inspire and motivate young researchers to actively engage with the public and with potential stakeholders, FameLab is all about finding the best new voices of science and engineering across the world.
Founded in 2005 by The Times Cheltenham Science Festival, FameLab, working in partnership with the British Council, has already seen more than 5,000 young scientists and engineers participate in over 23 different countries — from Hong Kong to South Africa, USA to Egypt.
Now, FameLab comes to Australia in a landmark collaboration with the British Council and Fresh Science — Australia’s very own science communication competition.
For more information about FameLab Australia, head to www.famelab.org.au